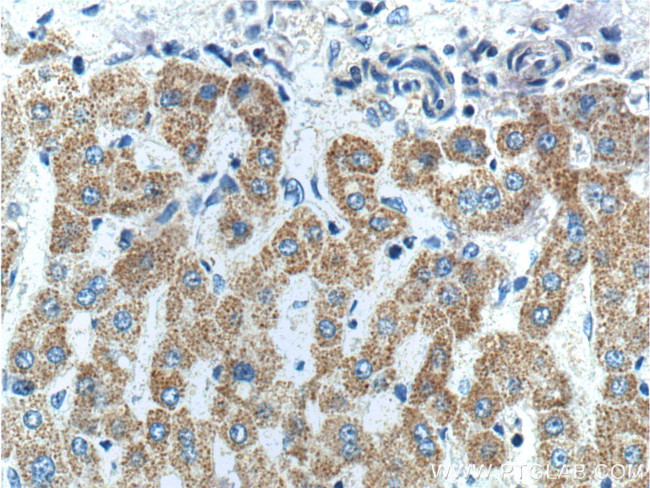
FNDC3B Antibody in Immunohistochemistry (Paraffin) (IHC (P))

Search
Proteintech
FNDC3B Polyclonal Antibody
{{$productOrderCtrl.translations['antibody.pdp.commerceCard.promotion.promotions']}}
{{$productOrderCtrl.translations['antibody.pdp.commerceCard.promotion.viewpromo']}}
{{$productOrderCtrl.translations['antibody.pdp.commerceCard.promotion.promocode']}}: {{promo.promoCode}} {{promo.promoTitle}} {{promo.promoDescription}}. {{$productOrderCtrl.translations['antibody.pdp.commerceCard.promotion.learnmore']}}
产品信息
22605-1-AP
种属反应
宿主/亚型
分类
类型
抗原
偶联物
形式
浓度
规格
纯化类型
保存液
内含物
保存条件
运输条件
产品详细信息
Immunogen sequence: VTMMMTDQI PLELPPLLNG EVAMMPHLVN GDAAQQVILV QVNPGETFTI RAEDGTLQCI QGPAEVPMMS PNGSIPPIHV PPGYISQVIE DSTGVRRVVV TPQSPECYPP SYPSAMSPTH HLPPYLTHHP HFIHNSHTAY YPPVTGPGDM PPQFFPQHHL PHTIYGEQEI IPFYGMSSYI TREDQYSKPP HKKLKDRQID RQNRLNSPPS SIYKSSCTTV YNGYGKGHSG GSGGGGSGSG PGIKKTERRA RSSPKSNDSD LQEYELEVKR VQDILSGIEK PQVSNIQARA VVLSWAPPVG LSCGPHSGLS FPYSYEVALS DKGRDGKYKI IYSGEELECN LKDLRPATDY HVRVYAMYNS VKGSCSEPV (3-370 aa encoded by BC039297 )
靶标信息
FNDC3B may be a positive regulator of adipogenesis.
仅用于科研。不用于诊断过程。未经明确授权不得转售。
生物信息学
蛋白别名: Factor for adipocyte differentiation 104; fibronectin domain-containing protein 3b; Fibronectin type III domain-containing protein 3B; HCV NS5A-binding protein 37; unnamed protein product
基因别名: 1600019O04Rik; AW550168; FAD104; FNDC3B; Kiaa4164; mKIAA4164; NS5ABP37; PRO4979; RGD1311673; UNQ2421/PRO4979/PRO34274; YVTM2421
UniProt ID: (Human) Q53EP0, (Mouse) Q6NWW9
Entrez Gene ID: (Human) 64778, (Rat) 294925, (Mouse) 72007